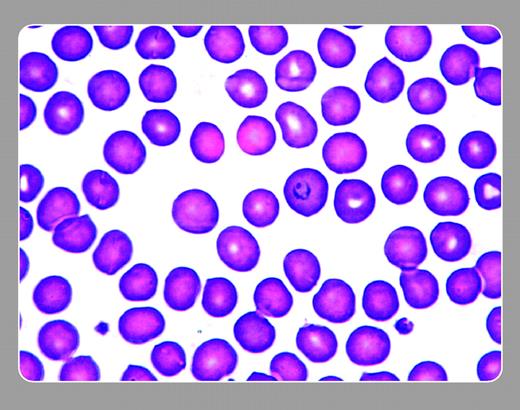
Figure 1. A 69-year-old man with lung cancer had been undergoing chemotherapy. Drug-associated moderate pancytopenia was treated with red cell transfusions. One week afterward, anemia became more pronounced. When unexplained fevers without serious leukopenia complicated his course, he was admitted for an assessment and antibiotics. A peripheral smear in this nontraveler explained his febrile course. A malarial parasite can be seen in the red blood cell just right of center. . / The Centers for Disease Control was alerted. Tracing blood donors to this patient uncovered an individual who recently returned to the United States after visiting family and friends in Central Africa. Embarrassingly, he admitted to not taking his antimalaria prophylaxis. . / Neil Abramson, Baptist Cancer Institute

A 69-year-old man with lung cancer had been undergoing chemotherapy. Drug-associated moderate pancytopenia was treated with red cell transfusions. One week afterward, anemia became more pronounced. When unexplained fevers without serious leukopenia complicated his course, he was admitted for an assessment and antibiotics. A peripheral smear in this nontraveler explained his febrile course. A malarial parasite can be seen in the red blood cell just right of center.
The Centers for Disease Control was alerted. Tracing blood donors to this patient uncovered an individual who recently returned to the United States after visiting family and friends in Central Africa. Embarrassingly, he admitted to not taking his antimalaria prophylaxis.
Neil Abramson, Baptist Cancer Institute
A 69-year-old man with lung cancer had been undergoing chemotherapy. Drug-associated moderate pancytopenia was treated with red cell transfusions. One week afterward, anemia became more pronounced. When unexplained fevers without serious leukopenia complicated his course, he was admitted for an assessment and antibiotics. A peripheral smear in this nontraveler explained his febrile course. A malarial parasite can be seen in the red blood cell just right of center.
The Centers for Disease Control was alerted. Tracing blood donors to this patient uncovered an individual who recently returned to the United States after visiting family and friends in Central Africa. Embarrassingly, he admitted to not taking his antimalaria prophylaxis.
Neil Abramson, Baptist Cancer Institute
Many Blood Work images are provided by the ASH IMAGE BANK, a reference and teaching tool that is continually updated with new atlas images and images of case studies. For more information or to contribute to the Image Bank, visit www.ashimagebank.org.
This feature is available to Subscribers Only
Sign In or Create an Account Close Modal